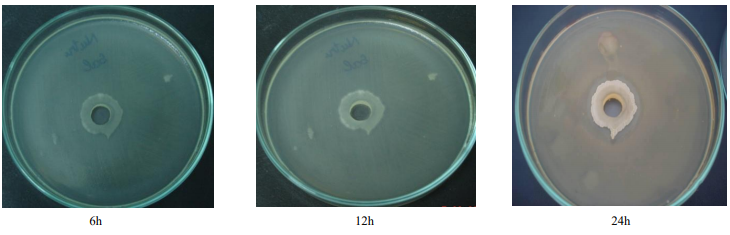
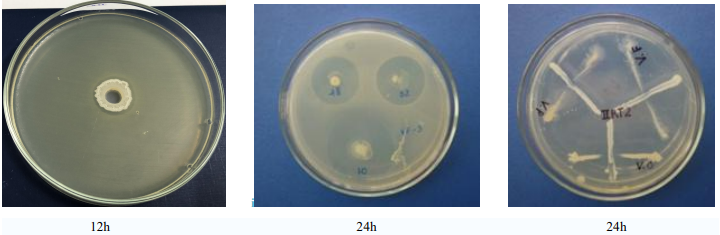

KHOẺ ĐƯỜNG RUỘT - TĂNG TRỌNG NHANH
PRO-ONE
Phòng bệnh đường ruột và kích thích tiêu hoá thức ăn
- Phòng bệnh đường ruột
- Kích thích tiêu hoá
- Cải thiện môi trường nuôi
- Tăng khả năng hấp thu thức ăn
Mã sản phẩm: AO
Tình trạng: Còn hàng
Giá: Liên hệ
Mua hàng
Gọi để đặt ngayHotline : 0983 024 940
TÍNH KHOA HỌC CỦA SẢN PHẨM
TÍNH CHẤT VI KHUẨN
1. Khả năng sống trong môi trường tương tự đường tiêu hóa
2. Khả năng kháng khuẩn
Trên đĩa môi trường có trải vi khuẩn gây bệnh E. coli, Salmonella typhi và Vibrio spp. Chúng tôi tiến hành cấy vi khuẩn có trong sản phẩm PRO-ONE vào. Sau khi vi khuẩn mọc, chúng tôi quan sát thấy các chủng vi khuẩn có lợi đã tăng sinh và tiết ra hợp chất kháng khuẩn tiêu diệt E. coli, Salmonella typhi và Vibrio spp, tạo ra vòng vô khuẩn.
2.1 Vi khuẩn E. coli
2.2 Vi khuẩn Salmonella
2.3 Vi khuẩn Vibrio SPP
Kết quả kiểm tra khả năng đối kháng Vibrio spp của các chủng Bacillus spp, bằng phương pháp cấy đường chữ thập cho thấy: vi khuẩn Bacillus spp. phân lập thể hiện khả năng đối kháng với cả 3 chủng V. cholerae, V. fluvialis, V. parahaemotilycus gây bệnh trên tôm. Hoạt tính đối kháng của các chủng Bacillus spp. đối với các chủng Vibrio thể hiện mạnh hơn sau 48 giờ và 72 giờ thí nghiệm. Vì hoạt chất ức chế sinh trưởng đối với các chủng Vibrio sinh bởi Bacillus spp. có thể trong các pha sinh trưởng sau của chu kì sinh trưởng vi khuẩn.
VIDEO VỀ SẢN PHẨM
Copyright © 2020 R.E.P Biotech JSC